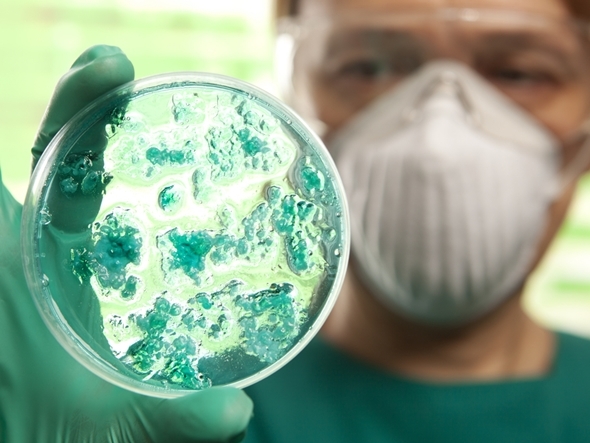

感染症への危機感薄く
20世紀には感染病を引き起こす病原体についての研究、すなわち、細菌学、ウイルス学、寄生虫病を含む寄生虫学分野において画期的な大きな発展がありました。その結果、これら病原体についての多くの情報を得ることができ、そのおかげで感染病にかからない予防、診断あるいは治療面における劇的な進歩がもたらされました。たとえば、さまざまな感染病診断法の開発、細菌および寄生虫による感染病に対して特効薬的な働きを示す抗生物質や抗菌剤の発見、それに続くさまざまな製剤の開発がなされました。感染病予防のためのワクチンも開発され広く応用されてきました。感染病で命を落とすという脅威は、20世紀当初に比べ大幅に減少しました。
日本でも、太平洋戦争敗戦からの復興の中で、環境衛生対策、疾病対策は熱心に取り組まれました。その結果、長らく国民病として恐れられてきた結核などの感染病の発生は激減しました。医学部を持ついくつかの大学に併設されていた結核撲滅のための研究所は、その役割を終え、研究対象を変え名称も変更して現在に至っています。
死亡率が高く恐れられていた感染病の多くは姿を消し、日本国での感染病そのものへの関心もすっかり低くなっています。それに変わり、生活習慣病のような非感染性の疾病の重要度が近年非常に高くなっています。
国際交流が生む危険も
一方、すっかり先進国の仲間入りをした日本の国際交流は大変盛んになっています。国外に進出した企業で、非常に多くの人たちが活躍しています。企業のみならず教育・研究機関の国際交流も活発になっています。日本国内の企業現場で働いている外国人は少なくなく、大学などでも多くの留学生を抱えています。私が知る限り、留学生の多くは、アジア、アフリカ等開発途上国からの人たちです。また、国外からのおびただしい数の観光客が日本を訪れています。
日本国内ではあまり話題になることがないのですが、これらの国々には現在日本では見られなくなってしまった過去の感染病がいまだに存在しています。日本国内で未発生の感染病もあります。したがって、海外赴任中あるいは旅行中にこれら感染病に罹患してしまう危険性は決して低くないことを認識する必要があります。逆に、海外からこれら感染病の病原体が持ち込まれる危険性も高まっています。

![2022年下半期リスクマネジメント・BCP事例集[永久保存版]](https://risk.ismcdn.jp/mwimgs/8/2/160wm/img_8265ba4dd7d348cb1445778f13da5c6a149038.png)




※スパム投稿防止のためコメントは編集部の承認制となっておりますが、いただいたコメントは原則、すべて掲載いたします。
※個人情報は入力しないようご注意ください。
» パスワードをお忘れの方